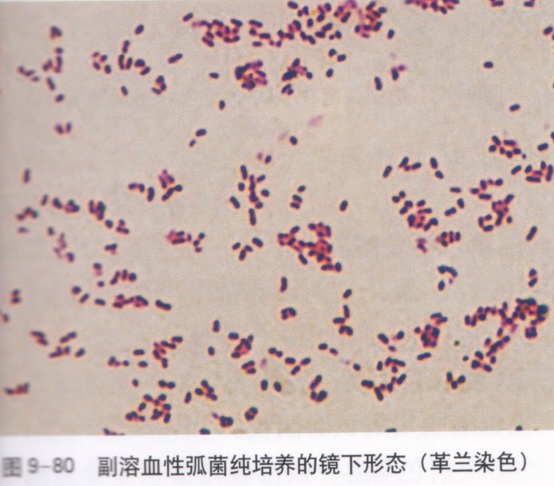
p>副溶血性弧菌(vibrio parahemolyticus),为革兰氏阴性杆菌,呈弧状

副溶血性弧菌

认识水产品的副溶血性弧菌
图片尺寸375x268
副溶血性弧菌 蓝绿色斗笠状菌落,h2s阴性
图片尺寸741x746
p>副溶血性弧菌(vibrio parahemolyticus),为革兰氏阴性杆菌,呈弧状
图片尺寸684x196
p>副溶血性弧菌(vibrio parahemolyticus),为革兰氏阴性杆菌,呈弧状
图片尺寸554x486
在应急检验的样品中检出副溶血性弧菌
图片尺寸640x478
副溶血弧菌
图片尺寸485x481
副溶血性弧菌食物中毒怎么办
图片尺寸600x375
第七节 副溶血性弧菌ppt
图片尺寸1080x810
副溶血性弧菌
图片尺寸484x372
副溶血性弧菌中毒是哪些食物
图片尺寸500x349
虾的主要致菌为:溶藻弧菌,副溶血弧菌,哈维氏弧菌,霍乱弧菌等.
图片尺寸1080x1920
副溶血性弧菌1常见病原菌二临床表现以胃肠道症状为主,包括腹泻,腹痛
图片尺寸618x800
副溶血性弧菌在tcbs上.jpg
图片尺寸500x373
人类疾病的主要有霍乱弧菌的古典生物型和埃尔托生物型,副溶血性弧菌
图片尺寸1192x1018
副溶血性弧菌_360百科
图片尺寸350x274
副溶血性弧菌食物中毒
图片尺寸400x303
夺命鱼广东男吃鱼后发烧拉肚子最终不治身亡
图片尺寸2592x1944
副溶血性弧菌
图片尺寸640x429
副溶血性弧菌食物中毒
图片尺寸400x188
副溶血弧菌简介ppt
图片尺寸1080x810